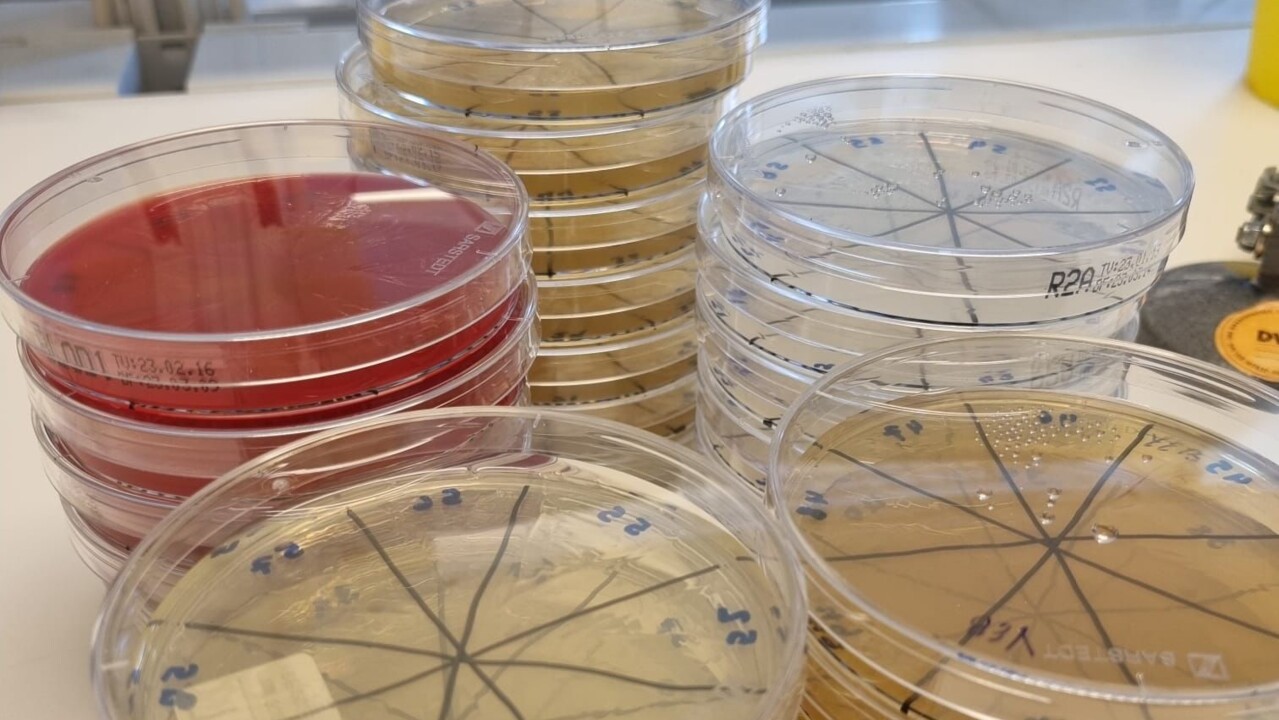
bakterier, växtvägg

Du surfar just nu på en begränsad version av umu.se. Vad innebär det här?
NYHET Ett nytt initiativ har lanserats av studenter – den stora, vissna växtväggen i hjärtat av Konstnärligt campus är på väg att återfödas. Det ger en möjlighet för studenter inom design och molekylärbiologi att utforska de interaktiva delarna av växtväggen samt bakteriers inverkan på växternas överlevnad inomhus.

Den nya växtväggen kommer att avtäckas i slutet av UID23 | Design Talks & Degree Show den 31 maj.
BildUID– Med väggens återkomst vill vi skapa möjligheter för interaktion mellan människor och växtväggen, liksom mellan de människor som kommer att vistas i detta utrymme. Vi har ägnat de senaste månaderna åt att försöka göra det mer konkret, säger William Roskaer, student på kandidatprogrammet i industridesign och en del av klimatgruppen vid Umeå Institute of Design.
Från att ha varit en livfull fasad som välkomnade människor från gångvägen vid Umeälven, har den tidigare grönskande utsidan av UID-verkstäderna på senare tid fungerat som en dyster påminnelse om en avlägsen vår. Men där andra såg förfall, såg studenterna i Umeå Institute of Designs klimatgrupp en möjlighet i den förgängliga växtväggen.
Tillsammans med partners från SLU Skogsvetenskap, Institutionen för molekylärbiologi, Umeå centrum för mikrobiell forskning (UCMR) och Vertisà AB tar de nu in ett unikt klimatekosystem för att inspirera till utbildning, sensoriskt engagemang och forskning.
Otroligt nog finns det ett fåtal växter som har kunnat överleva i den tidigare växtväggen utan vatten i flera månader. Vad fick dessa växter att överleva?

Hanna and Rana, examensarbetare, vid växtväggen.
BildDepartment of molecular biologyExamensarbetarna Hanna Forsberg och Rana Zeeb, från Institutionen för molekylärbiologi vid Umeå universitet, blev fascinerade av att det fanns några överlevande växter, och eftersom de visste att de inte hade skötts alls, riktades deras uppmärksamhet mot jorden eftersom det är en faktor som aldrig har förändrats sedan växterna installerades. På samma sätt var de nyfikna på luftkonditioneringen i närvaro av sådana växter.
– Det fick oss att undra om det fanns några bakterier som bara kunde hittas i överlevande växter och andra bakterier som bara kunde hittas i döda växter. Utifrån detta resonerade vi att om vi hittar sådana bakterier så kan vi anta att dessa bakterier främjar växternas överlevnad. De andra skadliga bakterierna som bara finns i döda växter tyder också på att det finns vissa miljöhälsovillkor för växter för att undvika förekomsten av sådana bakterier. Detta var utgångspunkten för vårt examensarbete, säger Rana Zeeb.
– Eftersom vi främst fokuserade på jord och luft analyserade vi inte de faktiska växterna, även om prover samlades in. Att fokusera på växter kommer att vara en annan viktig punkt som skulle behöva sin egen analys och hypotes. Det hade vi inte tid att göra, säger Hanna Forsberg.
Studenterna har tillbringat många timmar vid mikroskopet och lyckades till slut identifiera alla de bakterier som de hittade på väggen.
BildDepartment of molecular biologyDe få överlevande växterna har integrerats i den nya väggen som ett bevis på naturens inneboende motståndskraft.
En del av uppdraget är att ta reda på vilka växter som växer i den svenska naturen och som kan överleva och frodas i ett inomhusklimat. Men det slutliga väggkonceptet kommer inte bara att fokusera på den västerbottniska vegetationen som finns i våra lokala skogar. Exotiska växter, tillsammans med ätbara örter och grönsaker, kommer också att vara en del av den eklektiska mixen av grönska.
– I slutändan kom vi fram till ett par olika system som vi implementerar. På vänster sida kommer vi att visa upp en mängd olika växter från hela världen. Därifrån rör vi oss mot de växter som räddades från den gamla väggen. Huvuddelen kommer sedan att visa den svenska boreala skogen insvept i en konstnärlig panel gjord av levande mycelium, den svamp som producerar svampar, säger William Roskaer.
Förutom att odla kontakten mellan människor och den omgivande naturen finns det ett tydligt uppdrag med väggen att underlätta en starkare gemensam upplevelse i det fantastiska gemensamma utrymmet Arts Campus, som förbinder Umeå Institute of Design, Umeå School of Architecture, Umeå Academy of Fine Arts och den internationellt erkända konstplatsen Bildmuseet.
Avtäckningen av växtväggen sker på Designhögskolan på Konstnärligt campus den 31 maj kl 12.15.
Växtvägg är ett växande samarbete mellan Designhögskolan och den studentledda Klimatgruppen vid UID, Institutionen för molekylärbiologi och Umeå centrum för mikrobiell forskning (UCMR) vid Umeå universitet, SLU:s fakultet för skogsvetenskap och Vertisà AB.

I framtiden är en möjlighet att genomföra en mikromiljöanalys med hjälp av artificiell intelligens för identifiering av de provtagna bakteriekolonierna.
BildDepartment of molecular biology